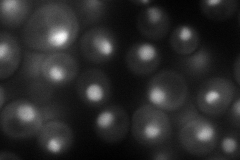
YPL178W
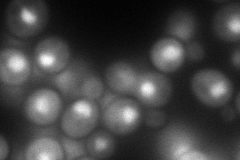
YPL178W

View description
Small subunit of the heterodimeric cap binding complex that also contains Sto1p, component of the spliceosomal commitment complex; interacts with Npl3p, possibly to package mRNA for export from the nucleus; contains an RNA-binding motif
Localization:
Intensity:
Fold change:
Significance:
-
C’ GFP library in SD

nucleus85.03 -
N' NOP1pr-GFP in SD
nucleolus113.605 -
N' TEF2pr-mCherry in SD
nucleus108.904 -
N' NATIVEpr-GFP in SD

nucleus81.4447 -
N' TEF2pr-VC and Cyto-VN in SD

nucleus50.8996 -
C’ GFP library in SD+DTT

nucleus79.990.94No -
C’ GFP library in SD+H2O2

nucleus46.280.54Yes -
C’ GFP library in Starvation Media

nucleus69.620.81No -
C’ GFP library on the background of Pup2-DaMP

nucleus -
C’ GFP library on the background of CCT mutant

nucleus76.26620.896886No
